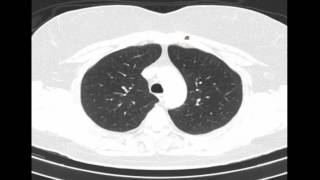
Radiologia para Estudiantes: TC PULMON Y TRAQUEA

Anatomía - Tráquea y Bronquios (Árbol bronquial, Vasos y Nervios, Relaciones)
226.14k views3221 WordsCopy TextShare

Dr. Carlos Andrés García
DESCARGA AQUÍ MIS DIAPOSITIVAS
https://www.udocz.com/profile/150926/carlosandresgarcia
Estudiante d...
Video Transcript:
muy bien en la clase de hoy vamos a hablar sobre la tráquea y los bronquios como saben de costumbre las diapositivas van a estar en la descripción para poder agarrarles trabajo y no se olviden de seguir a mi cuenta de Twitter @ vesalio termina en cero antes de comenzar el video hagan todo eso muy bien primero vamos a hablar de la trakia no tenemos que la trakia es un conducto elástico casi netamente cartilaginoso es un órgano impar medio y simétrico que se encuentra situado al principio en la parte anterior del cuello luego desciende penetra en
el orificio superior del tórax que estoy señalando en este momento para posteriormente ubicarse en el mediastino superior posterior a la al esternón no tenemos que este Organo se encuentra limitando hacia arriba con la laringe Por ende este va a comenzar en el disco intervertebral que sepa a c6 de c7 y termina a la altura del ángulo de Luis en el momento exacto donde esta tráquea se bifurca el ángulo de Luis no nos podemos olvidar que este ángulo se encuentra a la altura del disco intervertebral que separa a t4 de t5 eso es en cuanto a
su situación no sus dimensiones tenemos que esta traquia mide en promedio de 12 a 15 cm en el adulto su luz en sentido transversal mide 20 MM y en sentido vertical mide más o menos de 12 a 14 mm se dice que la luz de la tráquea es más o menos el mismo diámetro del meñique por eso se suele al momento de la intubación se suele Buscar un tubo que sea más o menos de las mismas dimensiones del meñique de la persona ya dicho esto pasemos a la forma la tráquea tiene la forma de un
tubo cilíndrico alargado que se encuentra aplanado en su parte posterior que posterior que después veremos Por qué se encuentra aplanado no por el momento les puedo decir que este se encuentra formado por una serie de de anillos cartilaginosos que están dispuestos en números de 16 a 20 los cuales están incompletos hacia atrás durante todo su recorrido la traquia va a presentar dos impresiones la primera que corresponde a la impresión tiroidea dejada por la glándula tiroides que se encuentra en la parte anterior del cuello la la otra impresión se encuentra en su porción toráxica Y corresponde
a la impresión aórtica que deja que deja El callado de la orta en su parte inferior izquierda ahora hablemos de las relaciones de este Órgano no Como he mencionado la traquia se encuentra tanto en el cuello como en el tórax Por ende hemos de describir sus relaciones en ambas zonas primero en su en la región cervical la traqueia va a estar cubierta por un plano superficial que es netamente muscular que corresponde al músculo externo tiroideo y al músculo externo cleido oido si sacamos este plano muscular vamos a poder observar el plano glandular que va a
estar estado por la glándula tiroides la cual se encuentra tapizado cubierto o envuelto por la fasia pretraqueal que es esta fascia que pueden observar aquí Esta es la fascia pretraqueal pero la hoja parietal ya que la hoja visceral de la misma fascia pretraqueal se encuentra separando la tiroides de la tráquea ya propiamente dicha no posterior a la glándula tiroides vamos a encontrar a la tráquea esta imagen eh comúnmente los profesores suelen tomarla no la tráquea Recuerden que siempre va a estar dilatada Mientras que el esófago va a estar colapsado tenemos ahí la glándula tiroides en
esta imagen de la derecha estoy señalando al ismo tiroideo que asciende hasta la laringe ahora tenemos que entre la tráquea y el esófago se encuentra un pequeño canal que corresponde al Canal traqueo esofágico por donde va a caminar el nervio laringo recurrente en esta imagen de la derecha también estoy señalando Este es el nervio Lingo recurrente derecho porque nace a la altura del de la arteria subclavia y el nervio que vemos acá nacer es el nervio larino recurrente izquierdo porque se origina a la altura del callado aórtico no por último tenemos que acá al lado
de la tráquea vamos a poder encontrar el paquete báculo nervioso del cuello que va a estar formado como ya sabemos por la carótida primitiva la yugular interna y el nervio vago o neumogástrico Eso es en su porción cervical ahora tenemos las relaciones en su porción toráxica tenemos que en su porción toráxica como ya mencioné la traquia se va a encontrar en la parte anterior del mediastino superior Por cierto en después de este video Subiré el video sobre mediastino para que puedan comprender lo que estoy hablando No las relaciones de la tráquea en el tórax hacia
delante va a ser el siguiente No primero vamos a encontrar al timo o vestigios del mismo en caso de que estemos hablando a un adulto y aquí si recordamos el timo comienza a bueno se atrofia ya casi por completo los 12 años por detrás del timo encontramos a este gran tronco el tronco venoso braquiocefálico izquierdo por detrás Y por debajo del tronco cefálico izquierdo encontramos al calla de la orta por este motivo existe una impresión aórtica en la traquia por último tenemos en las relaciones del tórax Es que la traqueia se va a relacionar con
el tronco arterial verco cefálico derecho y con la carótida primitiva izquierda de igual manera hacia atrás el esófago se encuentra posterior a la tráquea no en todo su recorrido ahora tenemos las relaciones en su bifurcación esto es muy importante es una pregunta que suelen tomar también Qué elementos se encuentran a la altura del ángulo de Luis son los siguientes no tenemos el ángulo external de Luis que es el que acabo de mencionar obviamente la bifurcación de la tráquea la desembocadura del conducto toráxico la desembocadura de la vena ácigos en el ángulo yugulo subclavio tenemos eh
la desembocadura de la gran vena linfática tenemos el disco intervertebral que separa t4 de t5 la base del óvulo apical del pulmón derecho la terminación del callado órtico y el origen de la aorta toráxica tenemos el origen del nervio larino recurrente izquierdo El ganglio de risberg y plexo cardíaco plexo pulmonar y ganglios inter bronquiales no con todas estas estructuras la bifurcación de la tráquea se encuentra en relación o se encuentran a la misma dura un último detalle antes de pasar a Constitución anatómica es que justo en esta bifurcación de la tráquea existe un pequeño espolón
conocido como el espolón traqueal o la carina esta carina Da inicio o origina a los bronquios extrapulmonares a continuación señalaré alguno de los elementos que acabo de mencionar que se encuentran a su izquierda No aquí tenemos en esta imagen tenemos a la tráquea que como ya dije se encuentra dilatada y al esófago que se encuentra colapsado Tenemos aquí a los nervios larinos recurrentes que caminan por los canales traqueo esofágicos Tenemos aquí El callado aórtico tenemos el tronco de la arteria pulmonar arteria pulmonar derecha arteria pulmonar izquierda el ganglio de risberg y plexo cardíaco acá en
esta imagen de la izquierda podemos encontrar ganglios linfáticos interbras encontramos el origen del lóbulos del acá el la base del lóbulo superior derecho del pulmón Esas son las únicas estructuras que podemos observar en esta imagen ahora hablemos de su Constitución anatómica no la traqueia se compone esencialmente de tres túnicas una mucosa una submucosa y una túnica fibrocartilaginosa que voy a describir a continuación no la mucosa como ya sabemos como casi en todo el recorrido de las vías aéreas está compuesta por un epitelio respiratorio en otras palabras Está compuesto por células cilíndricas ciliadas estratificadas con células
caliciformes es importante mencionar que esta mucosa presenta múltiples glándulas y receptores tunc genos luego tenemos a su submucosa que es relativamente delgada esta submucosa Va a estar compuesta por tejido conectivo fibroelástico que contiene múltiples glándulas eh glándulas mucosas y glándulas seromucosas por último tenemos la túnica fibroc inosa que es las que estoy señalando en este momento que esa túnica fibrocartilaginosa También incluye fibras de músculo liso No primero vamos a encontrar una membrana fibrosa esta membrana fibrosa se encuentra envolviendo casi en toda su extensión a la tráquea Y corresponde a la hoja visceral de la fascia
pretraqueal es decir que acá adelante estaríamos en eh podríamos encontrar a la glándula tiroides luego tenemos a los Anillos cartilaginosos o anillos traqueales que como ya mencioné son el número de 16 a 20 son anillos incompletos hacia atrás como pueden observar en la imagen del medio estos son los Anillos TR son incompletos hacia atrás ya que dejan un espacio que va a ser ocupado por el músculo traqueal de Rey seisen ese es el epónimo que le ponen a este músculo traqueal músculo traqueal de Rey seisen el cual tiene la función de poder es constrictor de
la traquea es constrictor de la tráquea y va a disminuir el diámetro de la luz de este Órgano no con como mencioné en la diapositiva anterior en la terminación de la tráquea justo en su bifurcación existe un espolón que es el que estamos viendo en este momento que corresponde al espolón traqueal o la carina donde da origen a los bronquios extrapulmonares ya estamos terminando casi el vídeo vamos a vasos Y nervios de la traquia no la traqueia va a estar irrigada por la arteria tiroida superior rama de la carótida externa por la arteria tiroide inferior
rama de la arteria subclavia esta Irrigación es porción cervical Ya que en su porción toráxica va a estar irrigada por algunas arterias bronquiales como podemos observar en la imagen de la izquierda y arterias tímicas del timo luego tenemos el drenaje venoso y el drenaje linfático no el drenaje venoso va a estar dado por las venas tiroideas inferiores que van a desembocar directamente al tronco venoso braquio cefálico izquierdo su drenaje linfático va a estar dado por los ganglios linfáticos paratraqueales ganglios linfáticos pretraqueal ganglios linfáticos interbras que van a desembocar ya sea en los ganglios cervicales profundos
inferiores o directamente en la gran vena linfática y en el conducto toráxico Tenemos aquí el conducto toráxico y acá tenemos a la gran vena linfática ambas desembocando en el ángulo yugulo subclavio ya por último tenemos a la inervación la inervación de la traqueia va a estar dada por la cadena simpática y por el nervio vago esto ha sido todo en cuanto a la tráquea y con esto ya podemos pasar al siguiente tema que corresponde a los bronquios los bronquios y el árbol bronquial se denomina bronquios a todos los conductos que resultan de la bifurcación de
la tráquea a la altura del ángulo external no su origen como mencioné anteriormente Está marcado por la presencia de un tabique de un cartílago conocido como el espolón traqueal o la carina para su estudio los bronquios se dividen en bronquios extrapulmonares que son los que estoy señalando en este momento y bronquios intrapulmonares que son los que se desarrollan dentro del parénquima pulmonar a continuación describiremos cada uno de ellos no en este momento señalando a todo el árbol bronquial tenemos Entonces los bronquios extrapulmonares también conocidos Como los bronquios principales los están señalados en este momento con
una línea de puntos como su nombre indica los bronquios extrapulmonares se encuentran por fuera del pulmón estos se originan de la bifurcación de la tráquea y terminan en el hilio pulmonar como parte de los elementos que forman el pedículo pulmonal tenemos que el bronquio derecho y el izquierdo presentan características distintas tales como su longitud su calibre y su dirección tenemos primero la longitud no el bronquio extrapulmonar izquierdo es mucho más largo que el derecho en promedio el izquierdo mide de 4.5 a 5 cm Mientras que el derecho mide únicamente de 2 a 2.5 cm pero
la la cosa cambia cuando hablamos del Calibre la luz el calibre del bronquio extrapulmonar derecho es mucho más grande que el bronquio extrapulmonar izquierdo midiendo este aproximadamente de 15 a 16 mm Mientras que el izquierdo mide de 10 a 11 mm esto Explica el hecho del Por qué el pulmón derecho predomina sobre el izquierdo por último tenemos la dirección la dirección del pulmón derecho como pueden observar es mucho más cerrada mientras que la del pulmón izquierdo es mucho más abierta Esto se debe a que el corazón se encuentra orientado hacia abajo hacia delante y hacia
la izquierda provocando Este cambio de dirección no como ya mencioné la terminación de ambos bronquios se efectúa en el hilo pulmonar si situado en su cara mediastínica Aquí tienen una imagen estamos mostrando aquí la cara mediastínica del del pulmón con todos los elementos que forman el pedículo pulmonar vemos aquí a los bronquios extrapulmonares vemos que este es un pulmón derecho porque tiene tres lóbulos no tenemos aquí el bronquio extrapulmonar penetrando en el hilo luego tenemos a las venas pulmonares a las perdón a las arterias pulmonares y a las venas pulmonares ahora hablemos de la Irrigación
y el drenaje linfático la Irrigación de los bronquios extrapulmonares van a estar dados por las arterias bronquiales que son ramas directas de la orta toráxica su drenaje venoso va a estar dado por las venas bronquiales estas venas bronquiales cuando hablemos de pulmón vamos a poder observar que confluyen en un solo en un tronco común que va a terminar la vena la la vena bronquial derecha termina en la vena ácigos mientras que la vena bronquial izquierda termina en la vena hemiácigos Eso es en cuanto a su drenaje venoso por último tenemos su drenaje linfático los numerosos
vasos colectores que salen del parénquima pulmonar van a terminar en los ganglios bronquio pulmonares que estoy señalando en este momento y en los ganglios traqueobronquiales inferiores ahora hablemos de los bronquios intrapulmonares se denomina bronquios intrapulmonares a todas las ramas que se desarrollan en el interior del pulmón o en el parénquima de este órgano describiré sucesivamente cada uno de estos bronquios intrapulmonares ya que cambian de nombre a medida que estos se dividen primero encontramos un bronquio pedicular principal como pueden observar aquí uno derecho y otro izquierdo este bronquio pedicular principal antes se pensaba que se dividía
por dicotomía Pero qué es esto de dicotomía es decir que la división se efectuaba por un sinnúmero de bifurcaciones Sin embargo se sabe actualmente que las demás ramas nacen como colaterales y no como terminales no estos bronquios pediculares principales van a dar origen de lado derecho a tres bronquios lobulares también conocidos Como los bronquios pediculares secundarios hay tres bronquios pediculares o lobulares secundarios de de lado derecho debido a que el pulmón derecho tiene tres lóbulos y el lado izquierdo por varas razones van a ha dos bronquios lobulares ya que el pulmón izquierdo solo tiene dos
lóbulos cada uno de estos bronquios lobulares van a dar bronquios segmentarios vamos a escribir primero el lado derecho y luego el lado izquierdo del bronquio lobular superior van a ser tres ramas un bronquio segmentario apical un bronquio segmentario anterior y un bronquio segmentario posterior luego tenemos al bronquio lobular medio del bronquio lobular medio van a ser una rama lateral un bronquio segmentario lateral y un bronquio segmentario medial finalmente tenemos que del del bronquio lobular inferior van a ser cinco ramas tenemos un bronquio segmentario superior superior o bronquio segmentario cardíaco Perdón o bronquio segmentario de Nelson
luego tenemos un bronquio segmentario medial o bronquio segmentario cardíaco tenemos luego un bronquio basal posterior un bronquio basal lateral y un bronquio basal anterior o anterobasal que es lo mismo de esta manera podemos ver que en general el pulmón derecho tiene 10 bronquios segmentarios repito apical posterior y anterior en el bronquio lobular superior lateral y medial en el bronquio lobular medio superior medial posterior lateral y anterior en el bronquio lobular inferior todo de lado derecho ahora tenemos del lado izquierdo tenemos que del lado izquierdo El bronquio lobular superior se va a dividir en dos troncos
un tronco superior o culmen y un tronco inferior o lingular el tronco superior o culmen va a dar un bronquio segmentario a pico posterior y un bronquio segmentario eh anterior repito el bronquio lubal superior se dim se divide en dos troncos uno superior o culmen y uno inferior o língula el br la división superior del bronquio lobular superior va a dar un bronquio segmentario a pico posterior y un anterior Mientras que el tronco lingular va a dar un bronquio lingular superior y un bronquio lingular inferior finalmente tenemos al bronquio lobular inferior este bronquio lobular inferior
va a dar una rama anteromedial una rama eh posterior y una rama lateral con esto podremos podemos llegar a la Ah Me faltó uno que es la que ven acá demorado que es la superior no con esto podemos llegar a la conclusión que el pulmón izquierdo va a contar con ocho bronquios segmentarios Mientras que el derecho tiene 10 A qué se debe esto al número de lóbulos que contiene cada pulmón no vamos a ver si tengo una imagen de lo que está descrito aquí posterior al bronquio segmentario esto ya incumbe al estudio de la histología
sin embargo las voy a mencionar de manera rápida no posterior a estos bronquios segmentarios va a seguir el bronquio segmentario mayor el bronquio segmentario menor y luego de esto tenemos al bronquio intralobulillar o bronquiolo terminal Este bronquiolo intralobulillar es el que penetra en un solo lobulillo pulmonar el cual termina microscópicamente Como saco alveolar donde como sabemos se realiza la hematosis la Irrigación de estos bronquios intrapulmonares de igual manera va a estar dado por las arterias bronquiales del lado derecho existe una arteria bronquial mientras que del lado izquierdo Existen dos arterias bronquiales el granaje venoso se
realiza por dos vías no puede conseguir una imagen buena de esto pero es netamente de teoría no tenemos que los bronquios a partir de los bronquios segmentarios van a ser las venas bronquiales que como ya mencioné la vena bronquial derecha termina eh en en la vena ácido mientras que a la izquierda termina en la vena enem mi acigo en cuanto a las demás ramificaciones que pertenecen al árbol bronquial es decir a el el bronquio segmentario mayor bronquio segmentario menor bronquiolo terminal y albiolo todas estas subdrenaje venosos se va a realizar Mediante los vasos venosos bronquiales
que son netamente diminutos Pero estas se van a anastomosarse de venas bronquio pulmonares de leord que van a terminar en la vena pulmonar que va se va a dirigir posteriormente como ya sabemos a la aurícula izquierda por último tenemos Bueno aquí tenemos un resumen de todo lo que he dicho en cuanto a segmentación pulmonar tenemos lóbulo superior lóbulo medio lóbulo inferior y cada uno con sus segmentos no esta imagen se las dejo es es es muy útil de hecho eh la pueden encontrar en el libro de anatomía de Pro ahí se las dejo no por
último tenemos Me faltó mencionar la inervación del lo que son los bronquios no los bronquios intrapulmonares y los bronquios extra
Related Videos

19:14
Anatomía - Diafragma (Origen, Inserciones ...
Dr. Carlos Andrés García
190,559 views

25:57
Anatomía - Pulmón (Segmentación, Caras, Vé...
Dr. Carlos Andrés García
110,707 views

17:47
🥇 Anatomy of the BRONCHI - (Main, Lobular...
Anatomía Fácil por Juan José Sánchez
211,524 views

23:51
Lymphatic System
Siebert Science
328,832 views

48:51
GENERALIDADES DEL SISTEMA RESPIRATORIO | N...
JD LECTURES
4,980 views

41:24
Anatomía - Músculos de la Pared Anterolate...
Dr. Carlos Andrés García
239,541 views

27:19
Anatomía - Estómago Part. II (Irrigación, ...
Dr. Carlos Andrés García
124,829 views

13:13
🥇 Anatomy of the TRACHEA. Easy, Quick and...
Anatomía Fácil por Juan José Sánchez
220,182 views

9:59
ÁRBOL BRONQUIAL: Bronquios principales, lo...
8vo Neurotransmisor
16,882 views

21:40
ANATOMÍA DE LOS PULMONES Y PLEURA
Anatomía Educando Para el Futuro.
8,393 views

41:21
Anatomía - Nariz y Cavidades Nasales (Linf...
Dr. Carlos Andrés García
239,374 views

18:34
The Respiratory System CRASH COURSE
ICU Advantage
321,153 views

26:31
Equilibrio ácido base #3 💉 Amortiguador r...
Dr. Roberto Añez
560,734 views

48:13
Anatomía y Fisiología Respiratoria Explica...
Tutorías Medicina Interna
143,042 views

22:20
Anatomía - Músculos del Tórax (Cintura Pec...
Dr. Carlos Andrés García
138,142 views

1:03:00
Anatomy and Physiology of Respiratory System
New Anatomy and Physiology Video
1,372,879 views

37:01
Anatomía | Sistema Respiratorio | Pulmón y...
Instituto Mortaji
53,846 views
22:46
Radiologia para Estudiantes: TC PULMON Y T...
Radiología para Estudiantes
59,693 views

50:55
HISTOLOGÍA: SISTEMA RESPIRATORIO
Dr. Cristopher Fuentes
33,401 views

48:13
Respiratory | Types of Hypoxia: Hypoxemic ...
Ninja Nerd
435,221 views